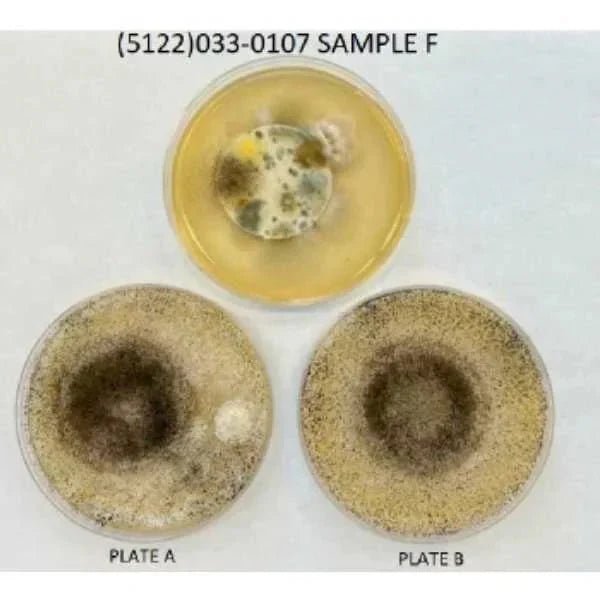

Call Us: 1-971-220-8360
Free Shipping

Pay No Sales Tax
30-Month Warranty
Call Us: 1-971-220-8360
Tents
Shop


How-To
CATEGORIES:
Featured Articles

THE LIT LIST 4 min read
What Is Glamping? Origins, Definition, Destinations & More

THE LIT LIST 5 min read
Essential Family Camping Checklist: What to Pack [PRINTABLE]

THE LIT LIST 6 min read
How to Set Up and Fold Up a Bell Tent

THE LIT LIST 8 min read
How to Maintain and Clean a Bell Tent

THE LIT LIST 4 min read
Backyard Glamping Checklist for an Unforgettable DIY Glampsite

THE LIT LIST 5 min read
Glamping in Northern California: 8 Luxury Sites
All articles

THE LIT LIST 6 min read
Perfect Your Brew: The Best Coffee Tips When Camping

THE LIT LIST 4 min read
Keep A Camping Tent Cool - Best Tent Fans, Flys and Air Conditioners

THE LIT LIST 3 min read
DIY Wood Center Pole For Bell Tent | Strengthening Your Pole
THE LIT LIST 3 min read
Is Your Tent Mold Resistant? AATCC 30 Test Explained

THE LIT LIST 5 min read
Practical 4-Season Tent Tips: Optimize for Year-Round Camping

THE LIT LIST 3 min read
3 Tips for Protecting Your Tent During Long-Term Use
Popular Blogs
Camping Gift Ideas for People Who Have Everything
The Best Portable Tent Heaters - Ways To Heat A Canvas Tent
Glamping in Northern California: 8 Luxury Sites
Waterproofing A Canvas Tent - Retreating Canvas
33 Camping Quotes to Inspire Your Next Adventure
What Is Glamping? Origins, Definition, Destinations & More
10 Tips for Staying Warm While Winter Camping
How to Maintain and Clean a Bell Tent
Essential Family Camping Checklist: What to Pack [PRINTABLE]
Backyard Glamping Checklist for an Unforgettable DIY Glampsite
BECOME AN INSIDER
We’ll periodically share inspiration, bell tent releases, special offers, and event notifications with ya.











